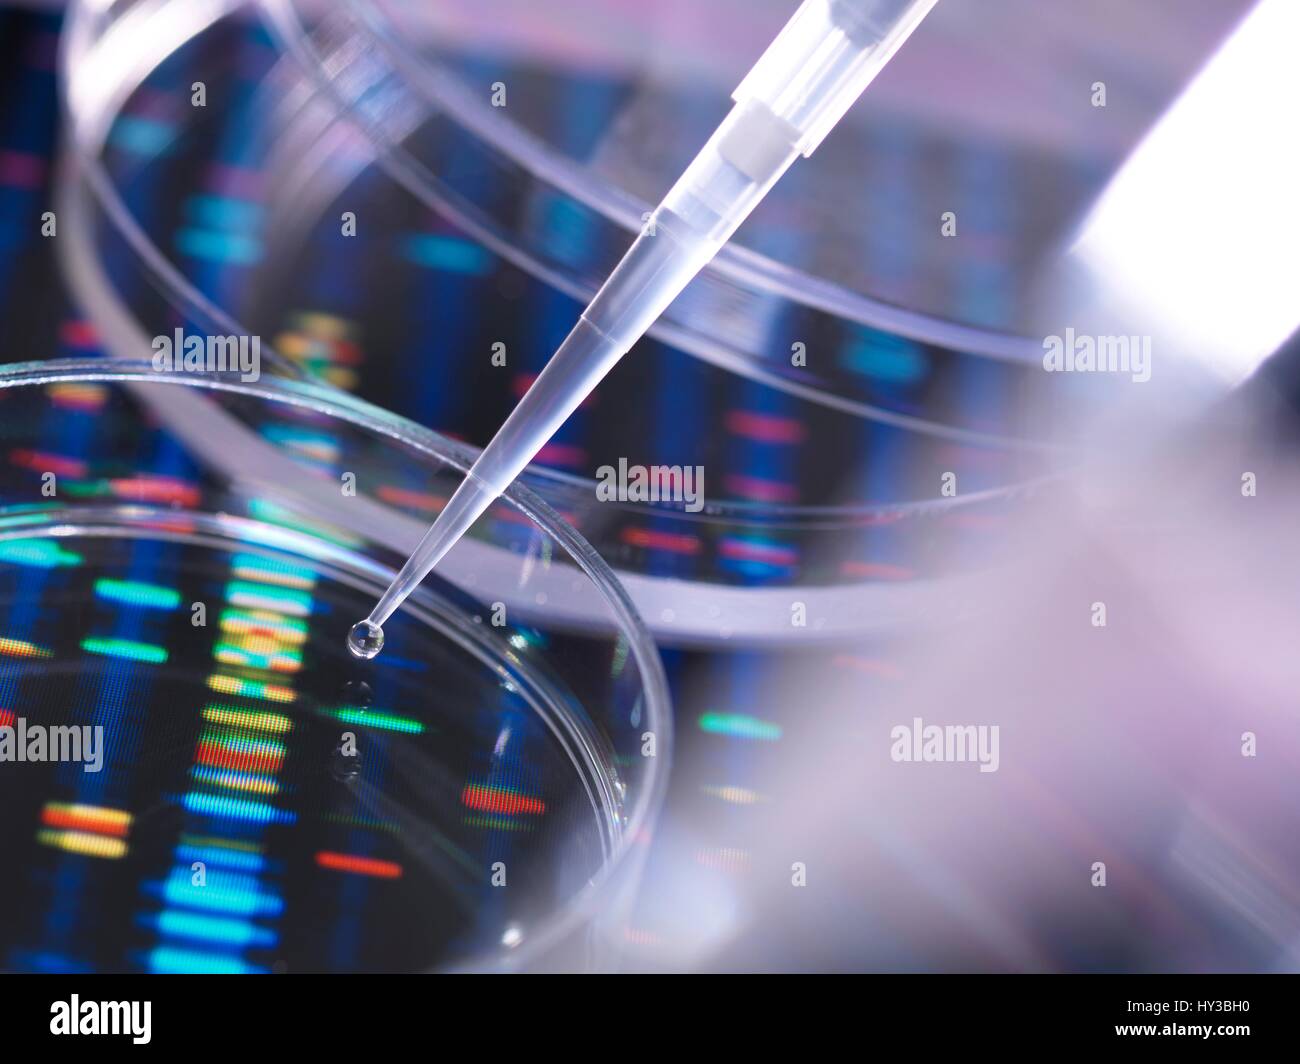

Геном лаб
Сколько же ты натерпелась моя
Гостеприимство армян
Общественные работа от службы занятости
Секционный состав
Впр 6кл биология
Бокс записаться на тренировку
Работа паспортного стола в борисове
Set edit настройка
Складки акварелью
Красивые большие балконы
Проба реберга расчет
Кабель греющий lite
Процессор intel core i7 2600 cpu
Геном лаб 105 фото